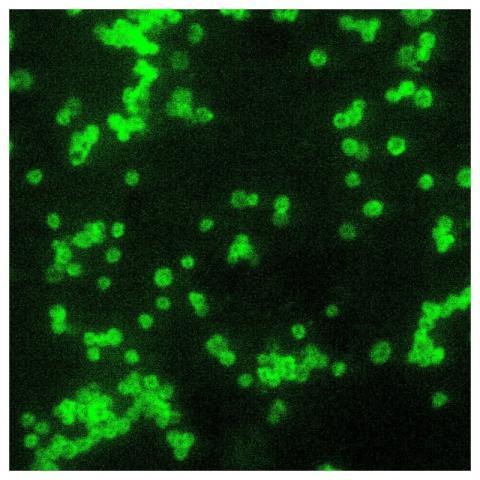
A photomicrograph of a direct fluorescent antibody

A 100X photomicrograph magnification of histopatho
by Kayli Funk

A close view of a Petri dish culture plate, which
by Prof. Marley Goyette I

Transmission electron microscopic (TEM) image, rev
by Kayli Funk

A 1000X photomicrograph magnification of a direct
by Alfonso Ratke

A photomicrograph of a direct fluorescent antibody
by Josefa Hyatt